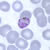
Gametocytes of P. malariae in a thin blood smear
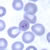
Rings of P. malariae in a thin blood smear
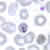
Rings of P. malariae in a thin blood smear
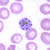
Schizonts of P. malariae in a thin blood smear.
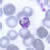
Trophozoites of P. malariae in a thin blood smear.

| Plasmodium
malariae: Blood Stage Parasites |
 |
Thin
Blood Smears. |
 |
Thick
Blood Smears. |
| Plasmodium
malariae: Gametocytes |
 |
Developing
gametocyte; Macrogametocyte (female); Microgametocyte (male). |
|
Gametocytes of P. malariae in a thin blood smear.
|
 |
 |
Gametocytes of P. malariae in a thick blood smear. |
| Plasmodium
malariae: Ring Stage Parasites |
 |
Normal red cell; Rings. |
|
Rings
of P. malariae in a thin blood smear. |
|
 |
 |
Rings
of P. malariae in a thick blood smear. |
| Plasmodium
malariae: Schizonts |
 |
Increasingly
mature schizonts. |
 |
Schizonts
of P. malariae in a thin blood smear. |
|
 |
 |
Schizonts
of P. malariae in a thick blood smear. |
| Plasmodium
malariae: Trophozoites |
 |
Increasingly
mature trophozoites; "band form". |
 |
Trophozoites
of P. malariae in a thin blood smear. |
 |
|